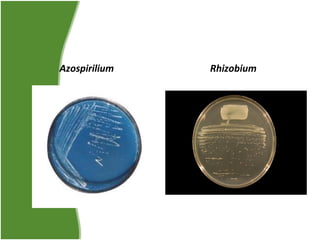
Azospirilium

Rhizobium
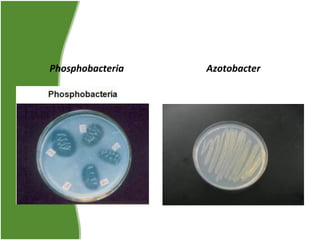
Phosphobacteria

Azotobacter

The document discusses biofertilizers as an alternative to chemical fertilizers. It provides background on how chemical fertilizers led to problems like soil pollution and reduced fertility over time. Biofertilizers use beneficial microorganisms instead to increase yields without environmental damage. Specific microorganisms discussed include Rhizobium, Azotobacter, phosphate solubilizing bacteria, and their roles in nitrogen fixation and phosphorus availability. The advantages of biofertilizers are their lower cost, eco-friendliness, and ability to supplement chemical fertilizers by 25%. Types of biofertilizers and their uses in composting and agriculture are also summarized.